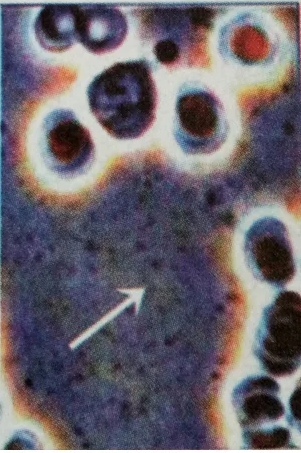
Butiran Lakteal

Apa yang Dapat Dilihat dalam Live Blood Analysis?
Berbagai kondisi dan ketidakseimbangan yang dapat dideteksi melalui pemeriksaan LBA

Sel Darah Normal

Netrofil

Eosinofil

Basofil

Monosit

Limfosit

Sel Plasma

Sel Darah Merah Rantai Pendek

Sel Darah Merah Rantai Panjang

Sel Darah Menggumpal

Sel Darah MERAH REULEOU

Protein Linkage